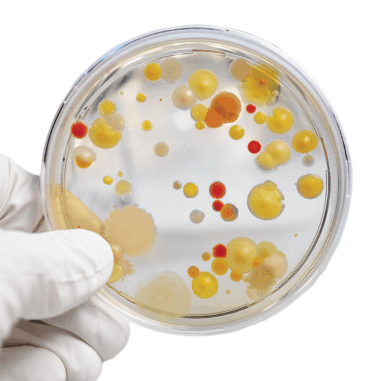
pietry dish of bacteria

Microbiologists Identify Bacteria with Ease
Table of Contents
Sample Collection and A Sterile Environment
Analyzing the Water to Identify Bacteria
How A Microbiologist Identifies Bacteria
Isolation Streaking
Gram Staining for Bacteria Identification
DNA Extraction and Machine Analysis to Identify Bacteria
Confirmatory Tests: Strengthening the Scientific Verdict
Consulting Bergey’s Manual: The Microbiologist’s Trusted Companion
Hidden Threats and The Microbiologist’s Crucial Role
The Significance of Bacterial Identification
Sample Collection and A Sterile Environment
Microbiologists start by collecting a sample, say, from drinking water. This sample is delicate, like a fragile puzzle piece waiting to be decoded.
To maintain its purity, scientists work in a sterile environment, like a laminar flow hood or clean room, where the air is carefully filtered to prevent contamination.

Analyzing the Water to Identify Bacteria
In the process of analyzing water for bacterial contamination, a crucial step involves running the collected water sample through a sterile filter apparatus.
This apparatus acts as a selective barrier, allowing only the bacteria present in the sample to pass through while trapping unwanted particles and contaminants.
Once the water, now carrying the captured bacteria, has passed through the filter, the filter itself becomes the focal point of study.
Carefully, the Microbiologist places the bacteria-laden filter onto the surface of a Petri dish filled with agar, a nutrient-rich gel that serves as the ideal environment for bacterial growth.
Here, within the confined space of the Petri dish, the filter acts as the foundation, hosting the bacteria obtained from the water sample.
Under precise laboratory conditions, these captured bacteria begin to multiply and form distinct colonies on the agar surface.
Each colony represents an entire community of bacterial cells, akin to individual neighborhoods within a city.
These colonies, visible to the naked eye, provide the groundwork for further study, observation, and eventual identification.

How A Microbiologist Identifies Bacteria
Isolation Streaking
To understand each colony’s identity, microbiologists perform isolation streaking. They use a loop to carefully pick a small portion of a colony and streak it onto a fresh agar plate.
It’s akin to isolating one house from a neighborhood. This step ensures that scientists study only one type of bacteria at a time, making their observations precise.

Gram Staining for Bacteria Identification
Now comes a magical moment in the lab – the gram staining. Scientists transfer a tiny sample from the isolated colony onto a glass slide. After heat-fixing, they apply special stains.
If the bacteria retain a purple color, they’re gram-positive, while pink indicates gram-negative. This color difference provides essential clues about the bacteria’s structure and guides microbiologists further.

DNA Extraction and Machine Analysis to Identify Bacteria
Delving into the genetic makeup, scientists extract DNA from the isolated bacteria. This genetic material is like the blueprint of life, holding secrets to the bacteria’s identity.
Specialized machines read this genetic code and compare it with known organisms in a vast library. This step acts as a powerful detective, narrowing down the search for the bacteria’s true name.
Confirmatory Tests: Strengthening the Scientific Verdict
In the pursuit of certainty, scientists employ confirmatory tests. By cross-verifying results from genetic analysis with earlier observations, microbiologists ensure accuracy.
Additional tests, such as the stab test, delve deeper into bacterial behavior, solidifying the identification process.

Consulting Bergey’s Manual: The Microbiologist’s Trusted Companion
Bergey’s Manual is a revered guide in the world of microbiology. Microbiologists turn to this comprehensive resource for in-depth knowledge.
Laden with information about various bacterial species, it serves as a trusted companion, offering guidance and additional tests to validate identifications.
In this fascinating voyage, microbiologists navigate the intricate paths of bacterial identification, revealing the hidden facets of these enigmatic microorganisms.
Through meticulous techniques, scientific expertise, and unwavering dedication, they decipher the secrets of the microbial world, one bacterium at a time.

Hidden Threats and The Microbiologist’s Crucial Role
In the realm of water safety, microbiologists stand as guardians, meticulously deciphering the secrets hidden within our drinking water.
Their expertise is not just a scientific endeavor; it’s a vital shield protecting public health. Through precise techniques, these experts unveil the specific types of bacteria residing in water samples, transforming the invisible threats into tangible knowledge.
Armed with this understanding, targeted strategies can be employed, ensuring the effective removal of harmful organisms. In the battle for pure and safe drinking water, microbiologists emerge as unsung heroes, safeguarding communities from potential health hazards.
The Significance of Bacterial Identification
The presence of bacteria in drinking water is more than just a concern—it’s a potential risk to our well-being.
Identifying these bacteria isn’t merely a scientific pursuit; it’s a fundamental necessity. By delving into the intricate world of microorganisms, microbiologists provide us with the crucial information needed to combat these invisible adversaries effectively.
Armed with this knowledge, water treatment processes can be tailored, ensuring the removal of specific bacteria and preserving the purity of our water supply.
In this battle against contamination, bacterial identification becomes our most potent weapon, allowing us to proactively protect the health and safety of communities far and wide.

About the Author

Bonnie Pellerin
Microbiologist
Bonnie Pellerin, a Biotechnology graduate and seasoned microbiologist, specializes in identifying bacteria and mold. Alongside her formulating chemist husband, she co-founded EarthSential, driven by their shared mission to create a safe haven free from harsh chemicals for their children and others. Bonnie’s expertise and dedication continue to shape the field of biotechnology and environmental safety.
The Essence of Essential Oils
in Plantsol’s Aromatherapy
by Bonnie Pellerin Ι Aug 14, 2023 Ι 5 Min Read
Your Signature Scent
EarthSential Essential Oil Cleaners
by Bonnie Pellerin Ι Aug 19, 2023 Ι 3 Min Read
The Power of Nature
How Peppermint, Clove and Thyme Work Together to Repel Rodents
by Minus Bite Ι May 3, 2023
Get the EarthSential Newsletter
Good deals, great advice & essentially necessary.